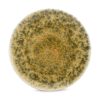
BonBistro farfurie Resto culoarea maro-Dinnerwear

– Design original. – Dimensiunile: 17,5 x 2 x 6 cm.
J-Line deschizator de sticle Antler culoarea negru face parte din categoria Bucătărie și bar Cooking & Baking de la brandul J-Line.
Produsul este oferit de magazinul online answear .
Magazin ieftin de imbracaminte, incaltaminte si accesorii.